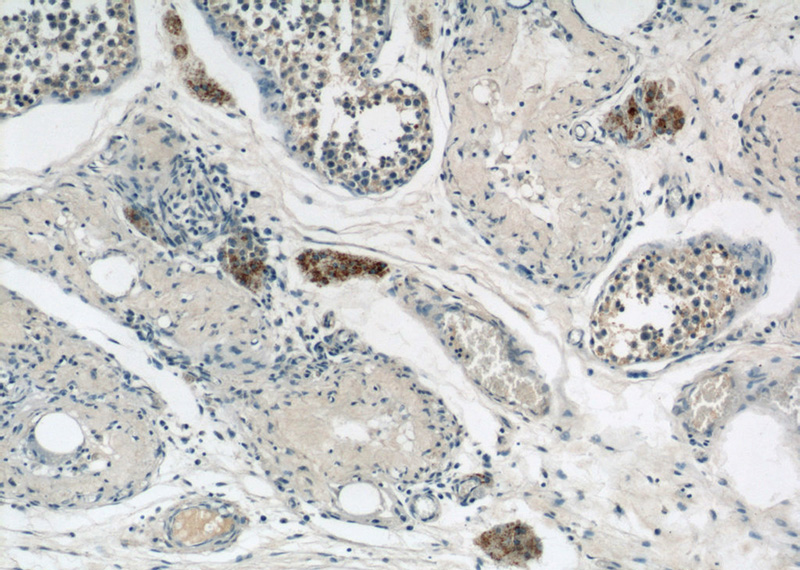
Immunohistochemical of paraffin-embedded human testis using Catalog No:109679(CYP11A1 antibody) at dilution of 1:50 (under 10x lens)

-
Product Name
CYP11A1 antibody
- Documents
-
Description
CYP11A1 Rabbit Polyclonal antibody. Positive IHC detected in human testis tissue, human placenta tissue. Positive WB detected in human placenta tissue, HeLa cells. Observed molecular weight by Western-blot: 49-52 kDa
-
Tested applications
ELISA, WB, IHC
-
Species reactivity
Human, Rat; other species not tested.
-
Alternative names
Cholesterol desmolase antibody; CYP11A antibody; CYP11A1 antibody; CYPXIA1 antibody; CytOChrome P450 11A1 antibody; CytOChrome P450(scc) antibody; P450SCC antibody
- Immunogen
-
Isotype
Rabbit IgG
-
Preparation
This antibody was obtained by immunization of CYP11A1 recombinant protein (Accession Number: NM_000781). Purification method: Antigen affinity purified.
-
Clonality
Polyclonal
-
Formulation
PBS with 0.02% sodium azide and 50% glycerol pH 7.3.
-
Storage instructions
Store at -20℃. DO NOT ALIQUOT
-
Applications
Recommended Dilution:
WB: 1:200-1:2000
IHC: 1:20-1:200
-
Validations

human placenta tissue were subjected to SDS PAGE followed by western blot with Catalog No:109679(CYP11A1 antibody) at dilution of 1:800
Immunohistochemical of paraffin-embedded human testis using Catalog No:109679(CYP11A1 antibody) at dilution of 1:50 (under 10x lens)

Immunohistochemical of paraffin-embedded human testis using Catalog No:109679(CYP11A1 antibody) at dilution of 1:50 (under 40x lens)
-
Background
CYP11A1 is the first enzyme of all steroidogenic pathways, its elimination results in syndromes of steroid deficiency, including electrolyte imbalance, aberrant gene regulation, and suppression of male sex organ development(PMID: 12145347). It ia also known as cytochrome P450C11A1, cytochrome P450scc and cytochrome P450, subfamily XIA. Expression of CYP11A1 has been a useful tool for monitoring the differentiation state of cells from varius endocrine tissues. Identification of CYP11A1 expression by 13363-1-AP detected a ~45kd band in human placenta, with respect to the reported band at 49-52kd by Roby, et al and Durkee, et al. The murine 32-kDa isoform of Cyp11a1 is not produced by omission of the first ATG-containing exon (as is the case for human CYP11A1) but perhaps by alternative translational initiation(PMID:19342447).
-
References
- Hanaue M, Miwa N, Takamatsu K. Immunohistochemical Characterization of S100A6 in the Murine Ovary. Acta histochemica et cytochemica. 45(1):9-14. 2012.
- Prasad M, Kaur J, Pawlak KJ, Bose M, Whittal RM, Bose HS. Mitochondria-associated endoplasmic reticulum membrane (MAM) regulates steroidogenic activity via steroidogenic acute regulatory protein (StAR)-voltage-dependent anion channel 2 (VDAC2) interaction. The Journal of biological chemistry. 290(5):2604-16. 2015.
- Vallée M, Vitiello S, Bellocchio L. Pregnenolone can protect the brain from cannabis intoxication. Science (New York, N.Y.). 343(6166):94-8. 2014.
- Schedel M, Jia Y, Michel S. 1,25D3 prevents CD8(+)Tc2 skewing and asthma development through VDR binding changes to the Cyp11a1 promoter. Nature communications. 7:10213. 2016.
Related Products / Services
Please note: All products are "FOR RESEARCH USE ONLY AND ARE NOT INTENDED FOR DIAGNOSTIC OR THERAPEUTIC USE"
